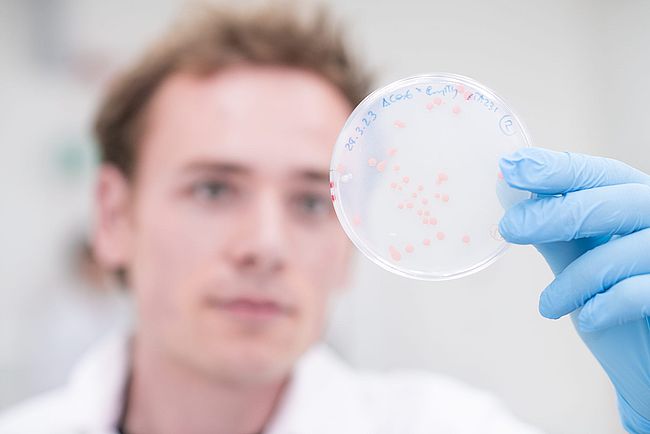
Biochemie

Schwerpunkte und Wahlbereiche
Im Masterstudiengang Chemistry gibt es lediglich Rahmenvorgaben durch die Studienordnung, wie viele Leistungspunkte in verschiedenen Fachrichtungen absolviert werden müssen. Welche das sind und welche konkrete Lehre innerhalb der Fachrichtung belegt wird, ist weitestgehend in der Hand der Studierenden. Dies ermöglicht maximale Flexibilität und die Chance, sich selbst zu verwirklichen und den Berufseinstieg nach dem Studium vorzubereiten. Im Masterstudiengang stehen sieben Fachrichtungen zur Wahl, von denen drei intensiver in den Blick genommen werden. Aber auch die anderen Fachrichtung sind zugänglich über einen allgemeinen Wahlbereich.
Die Fachrichtungen sind: Anorganische Chemie, Organische Chemie, Physikalische Chemie, Analytische Chemie, Makromolekulare Chemie, Theoretische Chemie, Energietechnik.
Zusätzlich gibt es thematisch-inhaltliche Schwerpunkte/Profile. Werden ausreichend Lehrveranstaltungen belegt, die einem oder mehreren dieser Profile zugeordnet sind, wird darüber zusammen mit dem Zeugnis ein Zertifikat ausgestellt.
Die thematischen Profile sind: Chemistry of Energy Storage and Conversion, Sustainable, Green and Environmental Chemistry, Chemistry of Molecular Materials Light Matter Interaction, Chemistry of Healthcare and Biomaterials